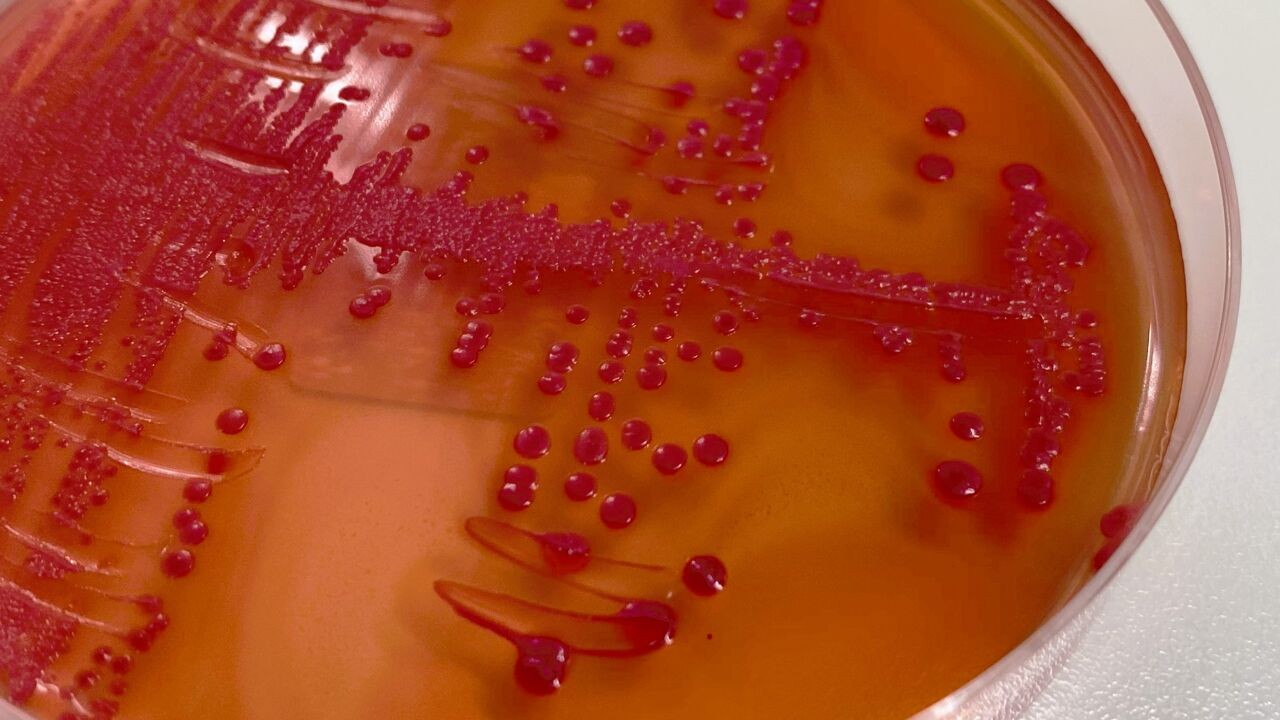

Homepage
.jpg%3Fitok%3DaeWOv9QT&w=3840&q=90)
#LikeMe is terug!
Mia ruilt een luxueus leven voor rust aan de Vlaamse kust. Maar al snel belooft haar nieuwe leven allesbehalve voorspelbaar te worden.
.jpg%3Fitok%3DEXeV_Sed&w=3840&q=90)
Beheersovereenkomst 2026-2030
VRT is klaar voor de toekomst: vertrouwen, vernieuwing en ambitie centraal in nieuwe beheersovereenkomst.
Op foto (vlnr): Vlaams minister van Brussel en Media Cieltje Van Achter, voorzitter van de Raad van Bestuur van VRT Frieda Brepoels, gedelegeerd bestuurder van VRT Frederik Delaplace.

De impact van VRT voel je overal
Het échte VRT-effect gaat verder dan wat je ziet, hoort of meemaakt op tv, radio, online en bij onze events. Het zit in wat er daarna gebeurt, ver nadat de kijk- en luistercijfers geteld zijn.
.jpg%3Fitok%3Drhp71UgN&w=3840&q=90)
Luister hier live naar onze radiostreams
Woon een opname bij
Altijd al eens in de studio willen zitten tijdens de opname van een show? Schrijf je nu in en we reserveren een zitje speciaal voor jou!
Win win win
Bij VRT loopt er altijd wel een leuke actie of wedstrijd. Kijk hoe je kan deelnemen en veel succes gewenst!
Kom eens op bezoek
Zin om eens langs te komen bij VRT? Je kan een rondleiding boeken door de studio's, inclusief een bezoekje aan onze beroemde toren.

Benieuwd naar het reilen en zeilen achter de schermen bij VRT? In onze maandelijkse nieuwsbrief kom je meer te weten
De nieuwsbrief is gratis én je kan je steeds uitschrijven. Lees ons privacy beleid.
.jpg%3Fitok%3Dhwvi7E2d&w=3840&q=90)
.jpg%3Fitok%3D_ltAH5qy&w=3840&q=90)























































.jpg%3Fitok%3DdU1rNBI6&w=3840&q=90)
.jpg%3Fitok%3D6oOW4XXF&w=3840&q=90)